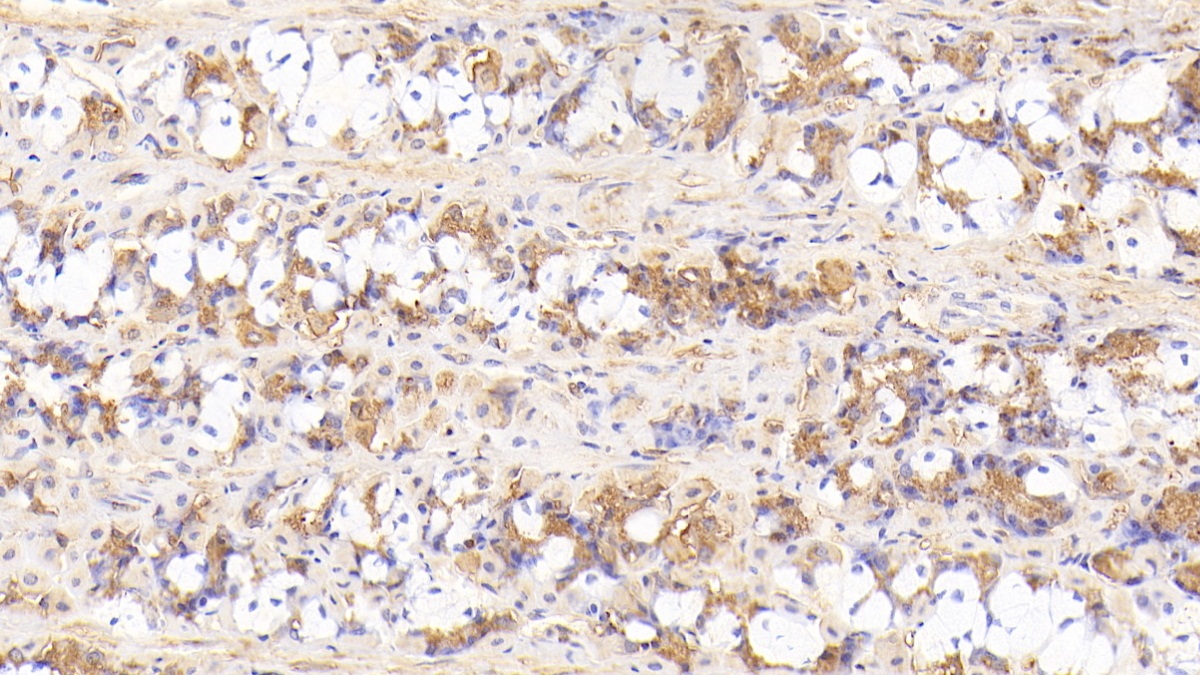
https://d1vffmuvmgkypt.cloudfront.net/image/ridacom_ltd/cloud_clone_corp/PRODUCT_SOURCE__CLOUD_CLONE__SUPPLIER__RIDACOM__ID__PAD349Hu01__1

Antigen
SEF
Reactivity
Human
(3)
Mouse
(2)
Rat
(2)
Application
Western Blotting
(6)
Immunocytochemistry
(3)
Immunohistochemistry
(3)
Immunoprecipitation
(3)
Positive Control
(3)
SDS-PAGE
(3)
Cell Culture
(1)
Category
Cell biology
(4)
Immunochemicals
(4)
Protein Biochemistry
(4)
Antibodies
(3)

Antigen:
Interleukin 17 Receptor D
Synonyms: SEF; IL17RLM; IL-17RD; IL17R-D; IL17Rhom; Interleukin-17 receptor-like protein
Reactivity:Human
Application:Cell Culture
Research area:Infection immunity
Preparation method:Escherichia coli
| 10µg | $352.00 | |
| 50µg | $880.00 | |
| 200µg | $1,760.00 |
| 1mg | $5,280.00 | |
| 5mg | $13,200.00 |

Antigen:
Interleukin 17 Receptor D
Synonyms: SEF; IL17RLM; IL-17RD; IL17R-D; IL17Rhom; Interleukin-17 receptor-like protein
Reactivity:Rat
Application:Positive Control; SDS-PAGE; Western Blotting
Research area:Infection immunity
Preparation method:Escherichia coli
| 10µg | $187.00 | |
| 50µg | $468.00 | |
| 200µg | $936.00 |
| 1mg | $2,808.00 | |
| 5mg | $7,020.00 |

Antigen:
Interleukin 17 Receptor D
Synonyms: SEF; IL17RLM; IL-17RD; IL17R-D; IL17Rhom; Interleukin-17 receptor-like protein
Reactivity:Mouse
Application:Positive Control; SDS-PAGE; Western Blotting
Research area:Infection immunity
Preparation method:Escherichia coli
| 10µg | $179.00 | |
| 50µg | $448.00 | |
| 200µg | $896.00 |
| 1mg | $2,688.00 | |
| 5mg | $6,720.00 |

Antigen:
Interleukin 17 Receptor D
Synonyms: SEF; IL17RLM; IL-17RD; IL17R-D; IL17Rhom; Interleukin-17 receptor-like protein
Reactivity:Human
Application:Positive Control; SDS-PAGE; Western Blotting
Research area:Infection immunity
Preparation method:Escherichia coli
| 10µg | $178.00 | |
| 50µg | $446.00 | |
| 200µg | $892.00 |
| 1mg | $2,676.00 | |
| 5mg | $6,690.00 |

Antigen:
Interleukin 17 Receptor D
Synonyms: SEF; IL17RLM; IL-17RD; IL17R-D; IL17Rhom; Interleukin-17 receptor-like protein
Host:Rabbit
Reactivity:Rat
Application:Western Blotting; Immunohistochemistry; Immunocytochemistry; Immunoprecipitation
Clonality:Polyclonal
Research area:Infection immunity
| 20µl | $114.00 | |
| 100µl | $266.00 | |
| 200µl | $380.00 |
| 1ml | $950.00 | |
| 10ml | $3,800.00 |

Antigen:
Interleukin 17 Receptor D
Synonyms: SEF; IL17RLM; IL-17RD; IL17R-D; IL17Rhom; Interleukin-17 receptor-like protein
Host:Rabbit
Reactivity:Mouse
Application:Western Blotting; Immunohistochemistry; Immunocytochemistry; Immunoprecipitation
Clonality:Polyclonal
Research area:Infection immunity
| 20µl | $108.00 | |
| 100µl | $252.00 | |
| 200µl | $360.00 |
| 1ml | $900.00 | |
| 10ml | $3,600.00 |
Antigen:
Interleukin 17 Receptor D
Synonyms: SEF; IL17RLM; IL-17RD; IL17R-D; IL17Rhom; Interleukin-17 receptor-like protein
Host:Rabbit
Reactivity:Human
Application:Western Blotting; Immunohistochemistry; Immunocytochemistry; Immunoprecipitation
Clonality:Polyclonal
Research area:Infection immunity
| 20µl | $105.00 | |
| 100µl | $245.00 | |
| 200µl | $350.00 |
| 1ml | $875.00 | |
| 10ml | $3,500.00 |



-APD349Hu01-000001.png)














-PAD349Ra01-000001.png)







